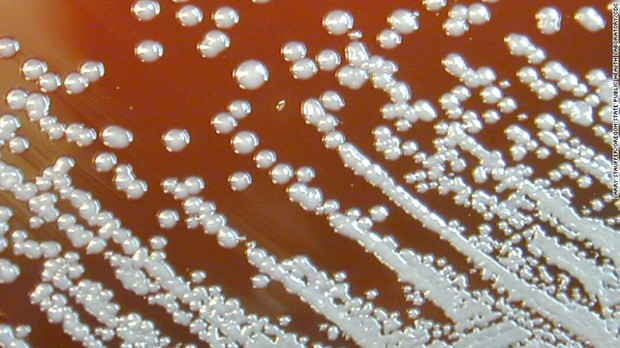
Thanh Hóa ra văn bản khẩn tăng cường phòng, chống bệnh Whitmore ảnh 1

Vi khuẩn B.pseudomallei gây bệnh Whitmore. (Nguồn: CNN)
Vi khuẩn B.pseudomallei gây bệnh Whitmore. (Nguồn: CNN)
Ngay sau khi nhận được thông tin từ Bệnh viện Nhi Trung ương về hai ca bệnh Whitmore, được chuyển đến từ Bệnh viện Nhi tỉnh Thanh Hóa, Sở Y tế Thanh Hóa đã có văn bản yêu cầu các đơn vị trong ngành tăng cường phòng, chống bệnh này.
Giám đốc Sở Y tế Thanh Hóa đề nghị Trung tâm Kiểm soát bệnh tật tỉnh, Trung tâm Y tế các huyện, thị xã, thành phố và các cơ sở khám bệnh, chữa bệnh trên địa bàn tăng cường tuyên truyền, hướng dẫn người dân, cộng đồng chủ động phòng bệnh Whitmore với biện pháp dự phòng cơ bản nhất là che chắn tốt đường hô hấp trong môi trường khói bụi, tăng cường công tác vệ sinh cá nhân, vệ sinh lao động; hạn chế tiếp xúc với đất hoặc nước bùn, đặc biệt là nơi bị ô nhiễm nặng.
[Người mắc Whitmore thường tiến triển nặng, tỷ lệ tử vong cao]
Đồng thời, khuyến cáo người dân khi có vết thương hở, vết loét hoặc vết bỏng cần tránh tiếp xúc với đất hoặc nước có khả năng bị ô nhiễm; trường hợp nếu bắt buộc phải tiếp xúc phải sử dụng băng chống thấm và cần được rửa sạch đảm bảo vệ sinh.
Khi có nghi ngờ nhiễm bệnh cần đến cơ sở y tế để được tư vấn, khám phát hiện, xét nghiệm xác định nhiễm vi khuẩn Whitmore để được điều trị kịp thời.
Bên cạnh đó, Giám đốc Sở Y tế Thanh Hóa yêu cầu các cơ sở khám bệnh, chữa bệnh trên địa bàn thường xuyên tập huấn cho nhân viên y tế tham gia khám phát hiện, điều trị người bệnh mắc Whitmore; cập nhật phác đồ chẩn đoán và điều trị bệnh Whitmore theo hướng dẫn của Bộ Y tế...
Các cơ sở khám chữa bệnh cần chuẩn bị đầy đủ các điều kiện, tổ chức tốt việc thu dung, khám, phân loại, điều trị bệnh Whitmore; dự trù vật tư, hóa chất, thuốc thiết yếu phục vụ chẩn đoán và điều trị, thực hiện tốt quy trình kỹ thuật chuyên môn, công tác kiểm soát nhiễm khuẩn, xử lý chất thải y tế, giám sát nhiễm khuẩn tại đơn vị.
Nhân viên y tế phải tuân thủ đúng hướng dẫn phòng ngừa chuẩn và phòng tránh lây chéo tại cơ sở y tế.
Theo thông tin từ Sở Y tế Thanh Hóa, Bệnh viện Nhi Trung ương đã thông báo cho đơn vị này về việc trong tuần đầu tháng 11/2022, Bệnh viện Nhi Trung ương phát hiện hai ca bệnh Whitmore được chuyển đến từ Bệnh viện Nhi tỉnh Thanh Hóa.
Trường hợp thứ nhất là bệnh nhân T.M.N. (sinh năm 2007, ở xã Mai Lâm, thị xã Nghi Sơn). N. được chuyển đến Bệnh viện Nhi Trung ương vào ngày thứ 12 sau khi khởi phát trong tình trạng nặng: phổi tổn thương, suy hô hấp, vẫn còn ban sẩn xuất huyết ở hai bàn tay.
Tại Bệnh viện Nhi Trung ương, bệnh nhân tiếp tục được thở máy, duy trì vận mạch, sử dụng IVIG, tiến hành lọc máu, xét nghiệm tìm căn nguyên. Mẫu cấy máu ngay từ khi vào viện đã phát hiện ra trực khuẩn gram âm Burkholderia pseudomallei vào ngày 3/11/2022. Các bác sỹ đã chẩn đoán trẻ bị shock nhiễm khuẩn/suy đa tạng/Whitmore.
Trường hợp thứ 2 là bệnh nhân L.N.Q., sinh năm 2012, ở xã Yên Mỹ, huyện Nông Cống.
Bệnh diễn biến 3 tháng, khởi đầu với biểu hiện sốt, sưng đỏ vùng mang tai 5 ngày, được chẩn đoán viêm tuyến nước bọt mang tai phải và điều trị tại Bệnh viện Đa khoa huyện Nông Cống 20 ngày không đỡ.
Sau đó, bệnh nhân được chuyển đến Bệnh viện Nhi Thanh Hóa chẩn đoán áp xe má phải được chích áp xe và điều trị nội trú 20 ngày sau đó ra viện tiếp tục điều trị nội trú 7 ngày.
Tuy nhiên, sau thời gian điều trị dài, vùng má phải tổn thương vẫn còn viêm và rỉ dịch mủ, đồng thời xuất hiện thêm cục to đau sau tai nên được chuyển Bệnh viện Nhi Trung ương khám, điều trị tiếp vào ngày 1/11/2022.
Tại Bệnh viện Nhi Trung ương, bệnh nhân được chích rạch khối áp xe, cấy dịch mủ từ khối áp xe và điều trị ngoại trú.
Kết quả cấy dịch mủ ngày 1/11/2022 đã phát hiện ra trực khuẩn gram âm Burkholderia pseudomallei. Chẩn đoán áp xe phần mềm vùng trước tai phải/Whitmore.
Bệnh Whitmore (tên gọi khác là bệnh Melioidosis) là một bệnh nhiễm trùng ở người và động vật do vi khuẩn Burkholderia Pseudomalle gây ra. Bệnh có biểu hiện lâm sàng rất đa dạng, khó chẩn đoán và có thể tử vong nếu không được chẩn đoán và điều trị kịp thời, đặc biệt ở những người có bệnh nền như tiểu đường, bệnh gan, thận, phổi mạn tính, suy giảm miễn dịch./.
![[Infographics] Hướng dẫn cách phòng ngừa căn bệnh nguy hiểm Whitmore](https://media.vietnamplus.vn/images/c06a2343df4164d2fe2c753277d10fd8dfa37ea834c4ea4fad1b1f768c864e14b5987c3294d5a0e0c0409cddd81db7fd541e65568c663acbed6a75ba2a62d1d171b0bb527366f33753bab3e655987598/infographicswhitmoreavatar.jpg.webp)
![[Infographics] Những điều cần biết về căn bệnh nguy hiểm Whitmore](https://media.vietnamplus.vn/images/c06a2343df4164d2fe2c753277d10fd8dfa37ea834c4ea4fad1b1f768c864e14e9fe8f4b4373ff209324194af17dce9b8c64261ef0dcf6d018e76c3e4bfa0a43b81cc02e8ad39d0721b4417e86f96300/ttxvnbenhwhitmoreavatar.jpg.webp)





































